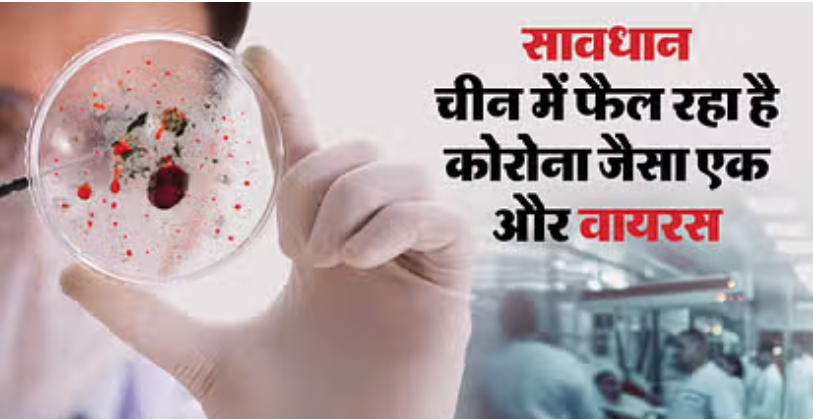

चीन में एक बार फिर कोरोनावायरस के जैसा ही एक और वायरस खतरा बनता दिख रहा है। हाल ही के दिनों में चीन से जो वायरल वीडियो सामने आए हैं, उनमें अस्पतालों के बाहर जबरदस्त भीड़ लगे देखा जा सकता है। इससे जुड़ी रिपोर्ट्स में दावा किया गया है कि चीन में इस वक्त संक्रमण फैलने की असल वजह ह्यूमन मेटान्यूमोवायरस (एचएमपीवी) है। एक रिपोर्ट में हॉन्गकॉन्ग के अखबार हॉन्गकॉन्ग एफपी ने दावा किया है कि चीन में यह वायरस तेजी से फैला है और लोगों में बड़े स्तर पर सांस से जुड़ी समस्याएं दर्ज की जा रही हैं। हालांकि, फिलहाल हॉन्गकॉन्ग में इस वायरस से जुड़े मामले कम हैं।
इतना ही नहीं चीन में एचएमपीवी के अलावा कुछ और वायरस के भी फैलने की खबरें हैं। इनमें इन्फ्लुएंजा ए, माइकोप्लासमा न्यूमोनिए और कोरोनावायरस के दोबारा फैलने से जुड़े दावे शामिल हैं। इसके अलावा कुछ अपुष्ट दावे हैं कि चीन ने स्थिति की गंभीरता को देखते हुए आपातकाल लगा दिया है। खासकर एचएमपीवी वायरस, जिसके लक्षण कोरोनावायरस संक्रमण के जैसे ही हैं को लेकर स्वास्थ्य अधिकारियों ने निगरानी बढ़ा दी है।
एचएमपीवी का किस पर और कितना असर?
- यह मुख्य तौर पर बच्चों पर असर डालता है। हालांकि, कमजोर प्रतिरोधक क्षमता वाले लोगों और बुजुर्गों पर भी इसका प्रभाव दर्ज किया गया है।
- इस वायरस की वजह से लोगों को सर्दी, खांसी, बुखार, कफ की शिकायत हो सकती है। ज्यादा गंभीर मामलों में गला और श्वांस नली के जाम होने से लोगों के मुंह से सीटी जैसी खरखराहट भी सुनी जा सकती है।
- कुछ और गंभीर स्थिति में इस वायरस की वजह से लोगों को ब्रोंकियोलाइटिस (फेफड़ों में ऑक्सीजन ले जाने वाली नली में सूजन) और निमोनिया (फेफड़ों में पानी भरना) की स्थिति पैदा कर सकता है। इसके चलते संक्रमितों को अस्पताल में भर्ती होने की जरूरत पड़ सकती है।
- चूंकि इसके लक्षण कोरोनावायरस संक्रमण और आम फ्लू से मिलते-जुलते हैं, इसलिए इन दोनों में अंतर बता पाना मुश्किल है। हालांकि, जहां कोरोनावायरस की महामारी हर सीजन में फैली थी। वहीं एचएमपीवी अब तक मुख्यतः मौसमी संक्रमण ही माना जा रहा है। हालांकि, कई जगहों पर इसकी मौजूदगी पूरे साल भी दर्ज की गई है।
- कोरोना के इतर इस वायरस के कारण ऊपरी और निचले दोनों श्वसन पथ में संक्रमण का खतरा हो सकता है।
- सामान्य मामलों में इस वायरस का असर तीन से पांच दिन तक रहता है।
वैक्सीन और उपचार के क्या तरीके हैं?
मौजूदा समय में ह्यूमन मेटान्यूमोवायरस से बचाव के लिए कोई टीका (वैक्सीन) मौजूद नहीं है। इसके अलावा एंटी वायरल दवाइयों का प्रयोग इस पर असर नहीं डालता। ऐसे में एंटी वायरल का प्रयोग इंसानों में प्रतिरोधक क्षमता बढ़ाने का काम कर सकता है।
इस वायरस से जूझ रहे लोगों को लक्षण हल्का करने के लिए कुछ दवाएं दी जा सकती हैं। हालांकि, वायरस को खत्म करने लायक उपचार अभी मौजूद नहीं है।
दुनिया के किन देशों में दिख चुका है इसका असर?
2023 में एचएमपीवी के कई मामले नीदरलैंड, ब्रिटेन, फिनलैंड, ऑस्ट्रेलिया, कनाडा, अमेरिका और चीन में दर्ज किए गए हैं। बीजिंग की कैपिटल मेडिकल यूनिवर्सिटी के यू’आन अस्पताल में श्वसन और संक्रामक रोग विभाग के मुख्य चिकित्सक ली तोंगजेंग के मुताबिक, मास्क पहनने, हाथों को लगातार धोने और प्रतिरोधक क्षमता बनाए रखने से बीमारी से राहत मिल सकती है।
वायरस ने चीन पर क्या असर डाला है?
वहीं इस मामले में चीन के रोग नियंत्रण प्राधिकरण ने शुक्रवार को बताया कि उसने अज्ञात कारणों से होने वाले निमोनिया के मामलों पर नजर रखने के लिए एक खास निगरानी प्रणाली शुरू की है। बयान में बताया गया कि सर्दियों के मौसम में श्वसन रोगों (सांस से जुड़ी बीमारियों) के मामलों में बढ़ोतरी होने की उम्मीद है। इस नई प्रणाली का उद्देश्य अधिकारियों को उन बीमारियों से निपटने में मदद करना है, जिनके कारण अभी तक समझ में नहीं आए हैं।
कोरोनावायरस के मामलों के आने के बाद जहां चीन की अधिकतर व्यवस्थाएं चरमरा गई थीं, वहीं अब इस वायरस के लिए चीनी सरकार ने प्रोटोकॉल तय करने का फैसला किया है। इसके लिए कई प्रयोगशालाओं में नियमों को स्थापित किया जाना है, जिससे श्वसन संबंधी बीमारियों को रिपोर्ट करने के साथ इनके नियंत्रण और बचाव के तरीकों पर भी काम किया जाएगा।
भारत ने क्या कहा?
इस बीच राष्ट्रीय रोग नियंत्रण केंद्र (एनसीडीसी) चीन में ह्यूमन मेटान्यूमोवायरस (एचएमपीवी) के प्रकोप की हालिया खबरों को देखते हुए देश में श्वसन और मौसमी इन्फ्लुएंजा के मामलों पर करीबी नजर रखे हुए है और अंतरराष्ट्रीय एजेंसियों के संपर्क में है। एक वरिष्ठ अधिकारी ने कहा, “हम स्थिति पर करीबी नजर रखे हुए हैं और विस्तृत जानकारी प्रदान करेंगे।”
स्वास्थ्य सेवा महानिदेशक (डीजीएचएस) डॉ. अतुल गोयल ने कहा कि ह्यूमन मेटान्यूमोवायरस सांस से संबंधित किसी भी अन्य वायरस की तरह है, जो सामान्य जुकाम का कारण बनता है। उन्होंने कहा कि यह युवाओं और अधिक आयु के लोगों में फ्लू जैसे लक्षण पैदा कर सकता है।
उन्होंने कहा, “चीन में ह्यूमन मेटान्यूमोवायरस (एचएमपीवी) के प्रकोप के बारे में खबरें आई हैं। हालांकि, हमने देश (भारत) में श्वसन प्रकोप के आंकड़ों का विश्लेषण किया है। दिसंबर 2024 के आंकड़ों में कोई उल्लेखनीय वृद्धि नहीं हुई है। हमारे किसी भी स्वास्थ्य संस्थान से बड़ी संख्या में मामले सामने नहीं आए हैं। मौजूदा स्थिति को लेकर घबराने की कोई बात नहीं है।”
डॉ. गोयल ने कहा, “किसी भी स्थिति में, सर्दी के दौरान श्वसन संक्रमण का प्रकोप बढ़ जाता है, जिसके लिए आमतौर पर हमारे अस्पतालों में आवश्यक चीजों की आपूर्ति और बिस्तरों की व्यवस्था की जाती है।” उन्होंने लोगों को श्वसन संक्रमण को रोकने के लिए अपनाई जाने वाली सामान्य सावधानियां बरतने की सलाह दी। उन्होंने कहा कि यदि किसी को खांसी और जुकाम है तो उन्हें दूसरों के संपर्क में आने से बचना चाहिए ताकि संक्रमण न फैले।